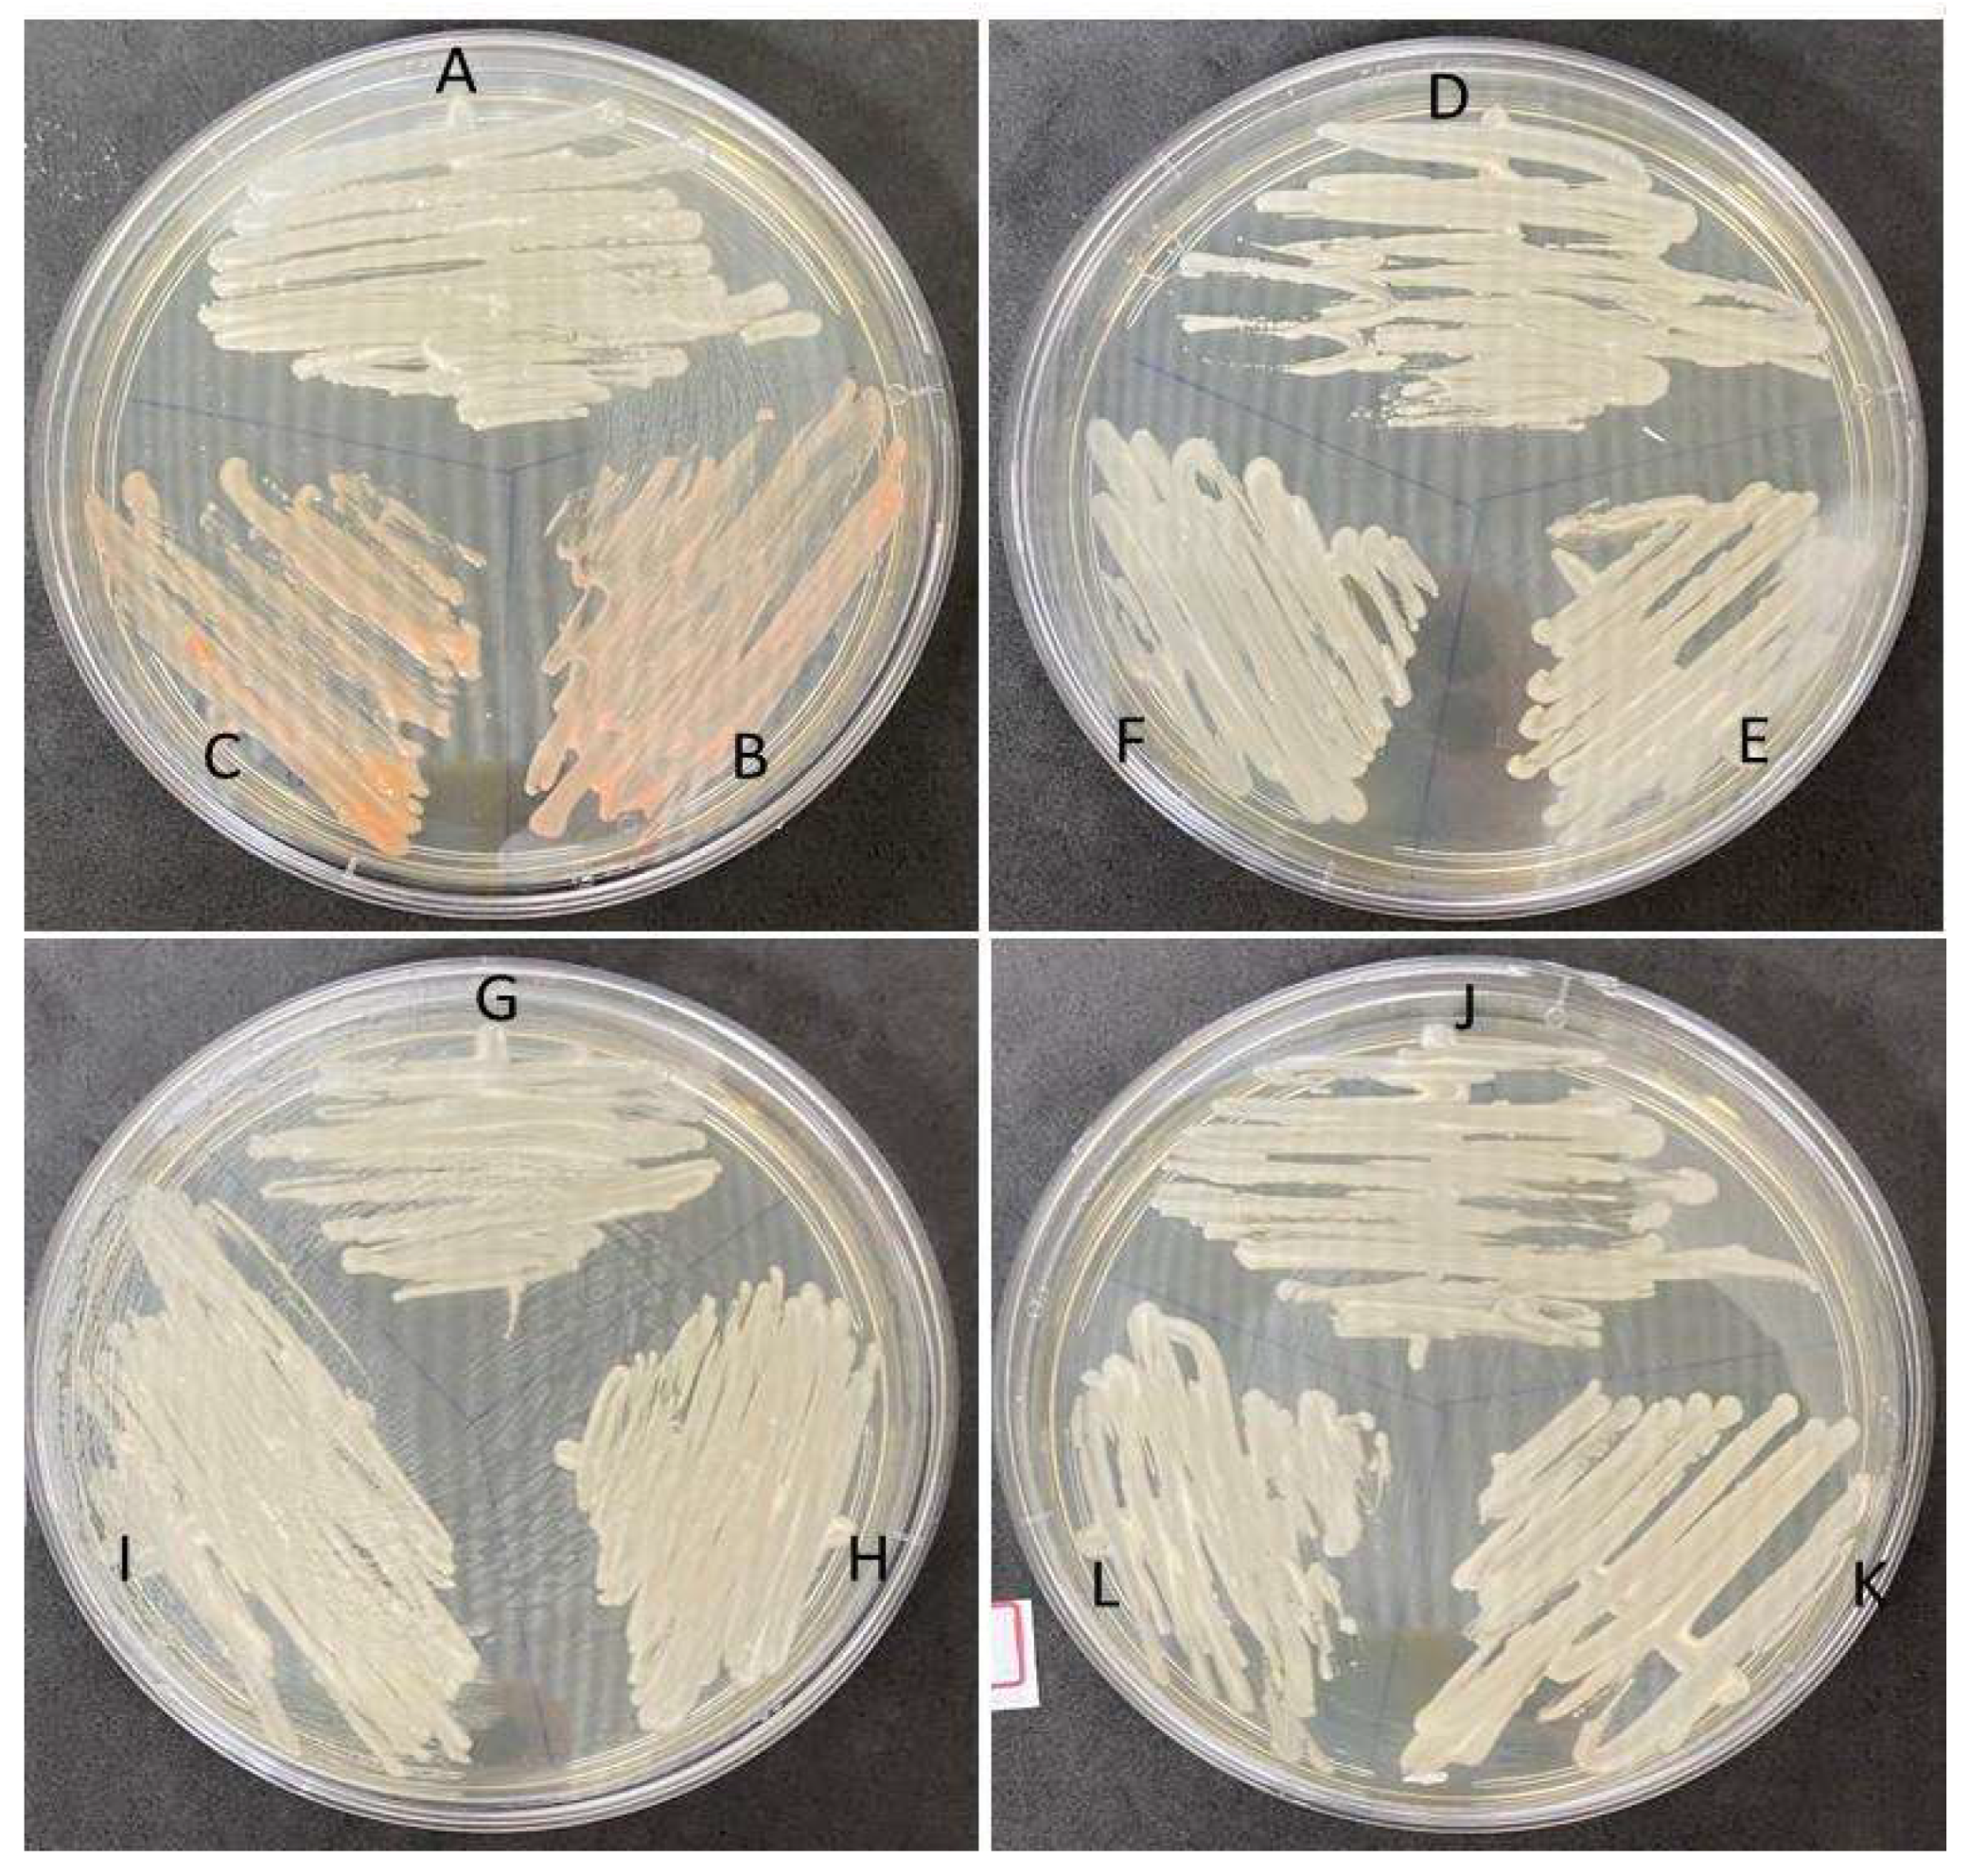
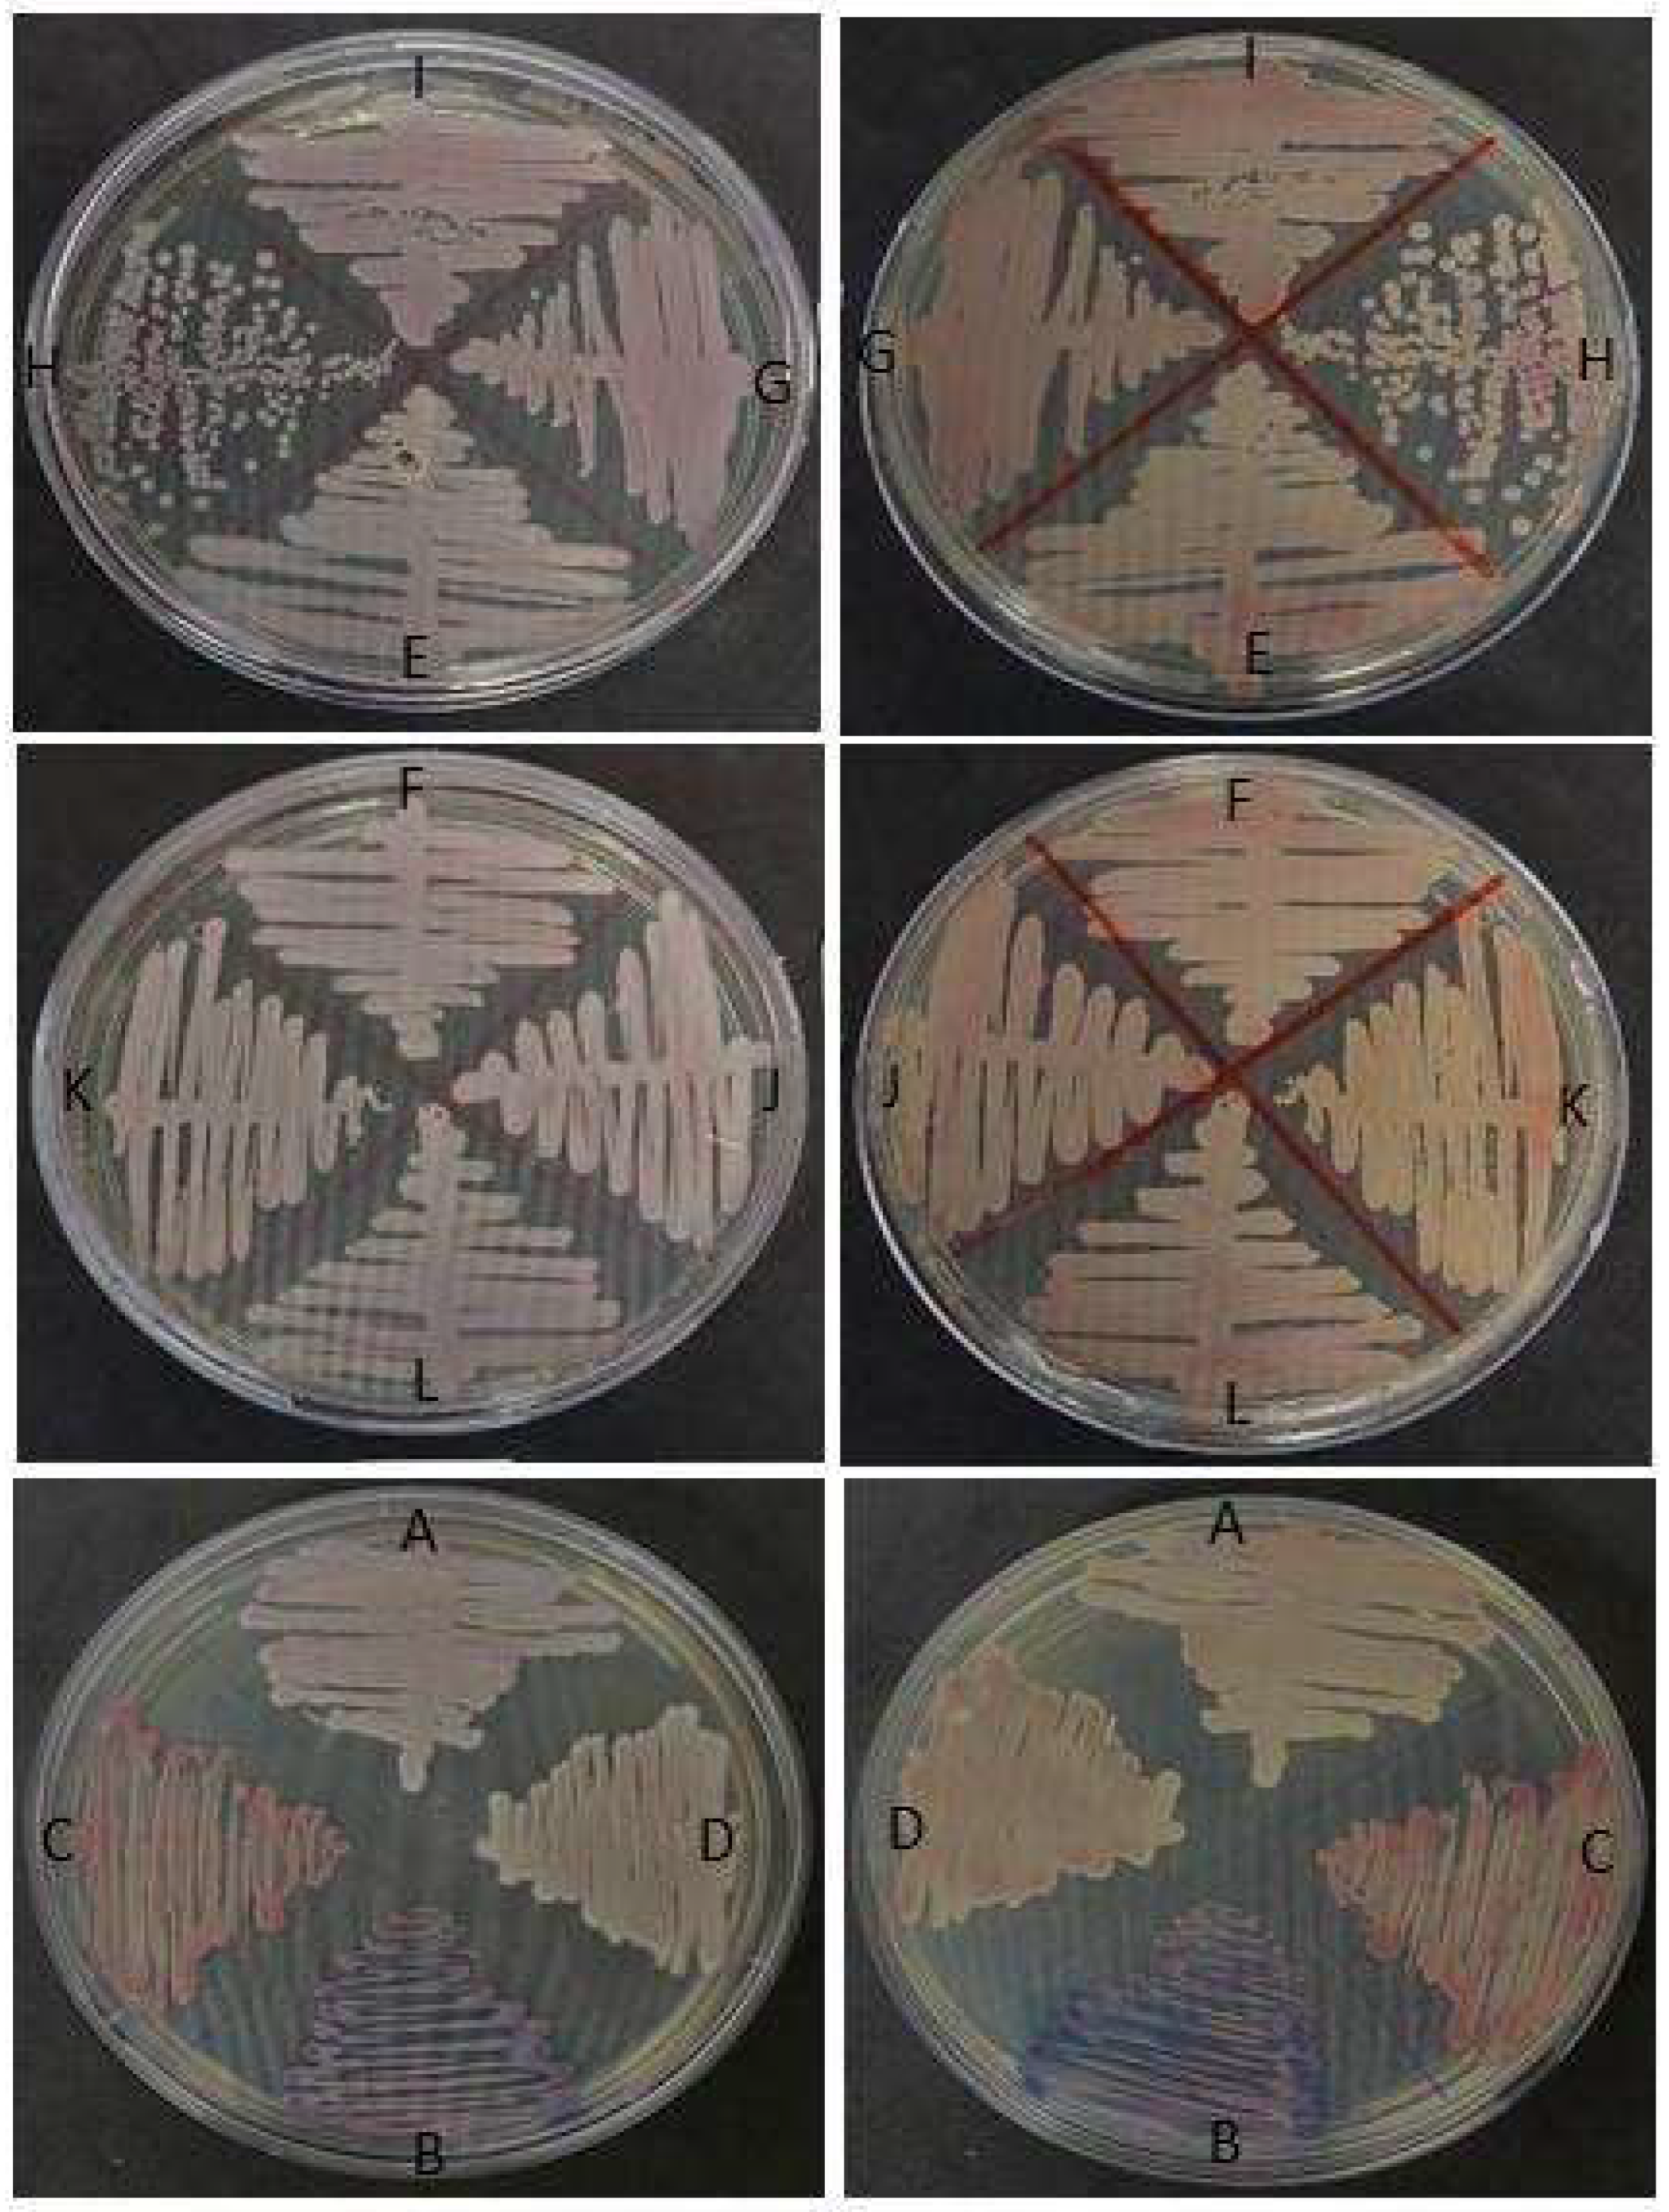

A Novel One Health Approach concerning Yeast Present in the Oral Microbiome of the Endangered Rio Skate (Rioraja agassizii) from Southeastern Brazil
Abstract
1. Introduction
2. Material and Methods
2.1. Sampling
2.2. Culture and Phenotypic Detection
2.3. MALDI-TOF Assay
2.4. Molecular Approach
3. Results
4. Discussion
5. Conclusions
Author Contributions
Funding
Data Availability Statement
Conflicts of Interest
References
- Etty, T.; Heyvaert, V.; Carlarne, C.; Farber, D.; Huber, B.; van Zeben, J. Transnational Climate Law. Transnatl. Environ. Law 2018, 7, 191–200. [Google Scholar] [CrossRef]
- Burge, C.A.; Eakin, C.M.; Friedman, C.S.; Froelich, B.; Hershberger, P.K.; Hofmann, E.E.; Petes, L.E.; Prager, K.C.; Weil, E.; Willis, B.L.; et al. Climate Change Influences on Marine Infectious Diseases: Implications for Management and Society. Annu. Rev. Mar. Sci. 2014, 6, 249–277. [Google Scholar] [CrossRef] [PubMed]
- Garcia-Solache, M.A.; Casadevall, A. Global Warming Will Bring New Fungal Diseases for Mammals. mBio 2010, 1, e00061-10. [Google Scholar] [CrossRef]
- de Crecy, E.; Jaronski, S.; Lyons, B.; Lyons, T.J.; Keyhani, N.O. Directed evolution of a filamentous fungus for thermotolerance. BMC Biotechnol. 2009, 9, 74. [Google Scholar] [CrossRef]
- Jones, E.B.G.; Ramakrishna, S.; Vikineswary, S.; Das, D.; Bahkali, A.H.; Guo, S.-Y.; Pang, K.-L. How Do Fungi Survive in the Sea and Respond to Climate Change? J. Fungi 2022, 8, 291. [Google Scholar] [CrossRef]
- Jones, E.B.G. Fifty years of marine mycology. Fungal Divers. 2011, 50, 73–112. [Google Scholar] [CrossRef]
- Minich, J.J.; Petrus, S.; Michael, J.D.; Michael, T.P.; Knight, R.; Allen, E.E. Temporal, Environmental, and Biological Drivers of the Mucosal Microbiome in a Wild Marine Fish, Scomber japonicus. mSphere 2020, 5, e00401-20. [Google Scholar] [CrossRef]
- Luna, G.M.; Quero, G.M.; Kokou, F.; Kormas, K. Time to integrate biotechnological approaches into fish gut microbiome research. Curr. Opin. Biotechnol. 2022, 73, 121. [Google Scholar] [CrossRef]
- Dulvy, N.K.; Fowler, S.L.; Musick, J.A.; Cavanagh, R.D.; Kyne, P.M.; Harrison, L.R.; Carlson, J.K.; Davidson, L.N.; Fordham, S.V.; Francis, M.P.; et al. Extinction risk and conservation of the world’s sharks and rays. eLife 2014, 3, e00590. [Google Scholar] [CrossRef] [PubMed]
- Dulvy, N.K.; Pacoureau, N.; Rigby, C.L.; Pollom, R.A.; Jabado, R.W.; Ebert, D.A.; Finucci, B.; Pollock, C.M.; Cheok, J.; Derrick, D.H.; et al. Overfishing drives over one-third of all sharks and rays toward a global extinction crisis. Curr. Biol. 2021, 31, 4773–4787.e8. [Google Scholar] [CrossRef]
- Romanelli, C.; Cooper, H.; Campbell-Lendrum, D.; Maiero, M.; Karesh, W.B.; Hunter, D.; Golden, C.D. Connecting Global Priorities: Biodiversity and Human Health, a State of Knowledge Review; WHO/CBD: Geneva, Switzerland, 2015; 344p. [Google Scholar]
- Romanelli, C.; Cooper, H.D.; de Souza, D.B.F. The integration of biodiversity into One Health. Rev. Sci. Technol. OIE 2014, 33, 487–496. [Google Scholar] [CrossRef]
- Virto, L.R. A preliminary assessment of the indicators for Sustainable Development Goal (SDG) 14 “Conserve and sustainably use the oceans, seas and marine resources for sustainable development”. Mar. Policy 2018, 98, 47–57. [Google Scholar] [CrossRef]
- Simon, J.C.; Marchesi, J.R.; Mougel, C.; Selosse, M.A. Host-microbiota interactions: From holobiont theory to analysis. Microbiome 2019, 7, 5. [Google Scholar] [CrossRef] [PubMed]
- Llewellyn, M.S.; Boutin, S.; Hoseinifar, S.H.; Derome, N. Teleost microbiomes: The state of the art in their characterization, manipulation and importance in aquaculture and fisheries. Front. Microbiol. 2014, 5, 207. [Google Scholar] [CrossRef] [PubMed]
- Gozlan, R.E.; Marshall, W.L.; Lilje, O.; Jessop, C.N.; Gleason, F.H.; Andreou, D. Current ecological understanding of fungal-like pathogens of fish: What lies beneath? Front. Microbiol. 2014, 5, 62. [Google Scholar] [CrossRef] [PubMed]
- Figureiredo, J.L. Manual de Peixes Marinhos do Sudeste do Brasil; Museu de Zoologia da Universidade de São Paulo: São Paulo, Brazil, 1977. [Google Scholar]
- Hozbor, N.; Manna, A.; Vooren, C.M. Atlantoraja castelnaui. International Union for Conservation of Nature—IUCN. IUCN Red List of Threatened Species. Version 2012.1. 2004. Available online: www.iucnredlist.org (accessed on 20 April 2023).
- Massa, A.; Hozbor, N.; Vooren, C.M. Atlantoraja cyclophora. International Union for Conservation of Nature—IUCN. IUCN Red List of Threatened Species. Version 2012.1. 2006. Available online: www.iucnredlist.org (accessed on 15 April 2023).
- San Martín, J.M.; Stehmann, M.F.W.; Kyne, P.M. Atlantoraja platana. International Union for Conservation of Nature—IUCN. IUCN Red List of Threatened Species. Version 2012.1. 2007. Available online: www.iucnredlist.org (accessed on 15 April 2023).
- Menni, R.C.; Stehmann, M.F.W. Distribution, environment and biology of batoid fishes off Argentina, Uruguay and Brazil. A review. Rev. Mus. Argent. Cienc. Nat. 2000, 2, 69–109. [Google Scholar] [CrossRef]
- Pinto, T.N.; Kohn, A.; da Costa, G.L.; Oliveira, L.M.A.; Pinto, T.C.A.; Oliveira, M.M.E. Candida guilliermondii as an agent of postpartum subacute mastitis in Rio de Janeiro, Brazil: Case report. Front. Microbiol. 2022, 13, 964685. [Google Scholar] [CrossRef]
- Stevenson, L.G.; Drake, S.K.; Shea, Y.R.; Zelazny, A.M.; Murray, P.R. Evaluation of matrix-assisted laser desorption ionization–time of flight mass spectrometry (MALDI-TOF) for the identification of clinically important yeast species. J. Clin. Microbiol. 2010, 48, 3482–3486. [Google Scholar] [CrossRef]
- Lindsley, M.D.; Hurst, S.F.; Iqbal, N.J.; Morrison, C.J. Rapid Identification of Dimorphic and Yeast-Like Fungal Pathogens Using Specific DNA Probes. J. Clin. Microbiol. 2001, 39, 3505–3511. [Google Scholar] [CrossRef]
- Tamura, K.; Dudley, J.; Nei, M.; Kumar, S. MEGA4: Molecular Evolutionary Genetics Analysis (MEGA) software version 4.0. Mol. Biol. Evol. 2007, 24, 1596–1599. [Google Scholar] [CrossRef]
- Saitou, N.; Nei, M. The neighbor-joining method: A new method for reconstructing phylogenetic trees. Mol. Biol. Evol. 1987, 4, 406–425. [Google Scholar]
- Tamura, K.; Nei, M.; Kumar, S. Prospects for inferring very large phylogenies by using the neighbor-joining method. Proc. Natl. Acad. Sci. USA 2004, 101, 11030–11035. [Google Scholar] [CrossRef] [PubMed]
- Felsenstein, J. Confidence limits on phylogenies: An approach using the bootstrap. Evolution 1985, 39, 783–791. [Google Scholar] [CrossRef] [PubMed]
- Garner, M.M. A Retrospective Study of Disease in Elasmobranchs. Vet.-Pathol. 2013, 50, 377–389. [Google Scholar] [CrossRef] [PubMed]
- Correia Costa, I.; Amorim de Oliveira, M.; Wosnick, N.; Ann Hauser-Davis, R.; Siciliano, S.; Nunes, J.L.S. Elasmobranch-associated microbiota: A scientometric literature review. PeerJ 2022, 10, e14255. [Google Scholar] [CrossRef]
- Crow, G.L.; Brock, J.A.; Kaiser, S. Fusarium solani Fungal Infection of the Lateral Line Canal System in Captive Scalloped Hammerhead Sharks (Sphyma lewini) in Hawaii. J. Wildl. Dis. 1995, 31, 562–565. [Google Scholar] [CrossRef]
- Fernando, N.; Hui, S.W.; Tsang, C.C.; Leung, S.Y.; Ngan, A.H.Y.; Leung, R.W.W.; Ngan, A.H.Y.; Leung, R.W.W.; Groff, J.M.; Lau, S.K.P.; et al. Fatal Fusarium solani species complex infections in elasmobranchs: The first case report for black spotted stingray (Taeniura melanopsila) and a literature review. Mycoses 2015, 58, 422–431. [Google Scholar] [CrossRef]
- Desoubeaux, G.; Debourgogne, A.; Wiederhold, N.P.; Zaffino, M.; Sutton, D.; Burns, R.E.; Frasca, S.; Hyatt, M.W.; Cray, C. Multi-locus sequence typing provides epidemiological insights for diseased sharks infected with fungi belonging to the Fusarium solani species complex. Med. Mycol. 2017, 56, 591–601. [Google Scholar] [CrossRef]
- Marancik, D.P.; Berliner, A.L.; Cavin, J.M.; Clauss, T.M.; Dove, A.D.M.; Sutton, D.A.; Wickes, B.L.; Camus, A.C. Disseminated fungal infection in two species of captive sharks. J. Zoo Wildl. Med. 2011, 42, 686–693. [Google Scholar] [CrossRef]
- Erlacher-Reid, C.D.; Nollens, H.H.; Schmitt, T.L.; Leger, J.S.; Sunico, S. Phaeohyphomycosis associated with ossification of the skull and cervical vertebrae in a swell shark (Cephaloscyllium ventriosum). J. Zoo Wildl. Med. 2016, 47, 1081–1085. [Google Scholar] [CrossRef]
- Bahram, M.; Hildebrand, F.; Forslund, S.K.; Anderson, J.L.; Soudzilovskaia, N.A.; Bodegom, P.M.; Bengtsson-Palme, J.; Anslan, S.; Coelho, L.P.; Harend, H.; et al. Structure and function of the global topsoil microbiome. Nature 2018, 560, 233–237. [Google Scholar] [CrossRef] [PubMed]
- Srinivasan, V.; Pierik, A.J.; Lill, R. Crystal Structures of Nucleotide-Free and Glutathione-Bound Mitochondrial ABC Transporter Atm1. Science 2014, 343, 1137–1140. [Google Scholar] [CrossRef] [PubMed]
- Fanning, S.; Mitchell, A.P. Fungal biofilms. PLoS Pathog. 2012, 8, e1002585. [Google Scholar] [CrossRef]
- Bornatowski, H.; Braga, R.R.; Barreto, R.P. Elasmobranchs consumption in Brazil: Impacts and consequences. In Advances in Marine Vertebrate Research in Latin America; Springer: Cham, Switzerland, 2017; pp. 251–262. [Google Scholar]
- de Souza-Araujo, J.; Hussey, N.E.; Hauser-Davis, R.A.; Rosa, A.H.; Lima, M.D.O.; Giarrizzo, T. Human risk assessment of toxic elements (As, Cd, Hg, Pb) in marine fish from the Amazon. Chemosphere 2022, 301, 134575. [Google Scholar] [CrossRef]
- Pincinato, R.B.M.; Gasalla, M.A.; Garlock, T.; Anderson, J.L. Market incentives for shark fisheries. Mar. Policy 2022, 139, 105031. [Google Scholar] [CrossRef]
- Burger, J. Fishing, fish consumption, and awareness about warnings in a university community in central New Jersey in 2007, and comparisons with 2004. Environ. Res. 2008, 108, 107–116. [Google Scholar] [CrossRef] [PubMed]
- Smith, M.; Love, D.C.; Rochman, C.M.; Neff, R.A. Microplastics in Seafood and the Implications for Human Health. Curr. Environ. Health Rep. 2018, 5, 375–386. [Google Scholar] [CrossRef]
- FAO. The State of Food and Agriculture Social Protection and Agriculture: Breaking the Cycle of Rural Poverty; FAO: Rome, Italy, 2015. [Google Scholar]
- Nazir, R.; Shen, J.-P.; Wang, J.-T.; Hu, H.-W.; He, J.-Z. Fungal networks serve as novel ecological routes for enrichment and dissemination of antibiotic resistance genes as exhibited by microcosm experiments. Sci. Rep. 2017, 7, 15457. [Google Scholar] [CrossRef]
- Fisher, M.C.; Alastruey-Izquierdo, A.; Berman, J.; Bicanic, T.; Bignell, E.M.; Bowyer, P.; Bromley, M.; Brüggemann, R.; Garber, G.; Cornely, O.A.; et al. Tackling the emerging threat of antifungal resistance to human health. Nat. Rev. Genet. 2022, 20, 557–571. [Google Scholar] [CrossRef]
- Woodall, L.C.; Sanchez-Vidal, A.; Canals, M.; Paterson, G.L.J.; Coppock, R.; Sleight, V.; Calafat, A.; Rogers, A.D.; Narayanaswamy, B.E.; Thompson, R.C. The deep sea is a major sink for microplastic debris. R. Soc. Open Sci. 2014, 1, 140317. [Google Scholar] [CrossRef]
- Kettner, M.T.; Rojas-Jimenez, K.; Oberbeckmann, S.; Labrenz, M.; Grossart, H.-P. Microplastics alter composition of fungal communities in aquatic ecosystems. Environ. Microbiol. 2017, 19, 4447–4459. [Google Scholar] [CrossRef] [PubMed]
- Trofa, D.; Gacser, A.; Nosanchuk, J.D. Candida parapsilosis, an emerging fungal pathogen. Clin. Microbiol. Rev. 2008, 21, 606–625. [Google Scholar] [CrossRef] [PubMed]
- Silva, S.; Negri, M.; Henriques, M.; Oliveira, R.; Williams, D.W.; Azeredo, J. Candida glabrata, Candida parapsilosis and Candida tropicalis: Biology, epidemiology, pathogenicity and antifungal resistance. FEMS Microbiol. Rev. 2012, 36, 288–305. [Google Scholar] [CrossRef] [PubMed]
- Kano, R.; Sakamoto, Y.; Hanahachi, A.; Kamata, H.; Fukuda, Y.; Fujiwara, K.; Hasegawa, A. Molecular Identification of Candida Parapsilosis from Crop Mucosa in a Cockatiel. J. Vet.-Diagn. Investig. 2001, 13, 437–439. [Google Scholar] [CrossRef] [PubMed]
- Sidrim, J.J.C.; Maia, D.C.B.d.S.C.; Brilhante, R.S.N.; Soares, G.D.P.; Cordeiro, R.A.; Monteiro, A.J.; Rocha, M.F.G. Candida species isolated from the gastrointestinal tract of cockatiels (Nymphicus hollandicus): In vitro antifungal susceptibility profile and phospholipase activity. Vet.-Microbiol. 2010, 145, 324–328. [Google Scholar] [CrossRef] [PubMed]
- Lamm, C.G.; Grune, S.C.; Estrada, M.M.; McIlwain, M.B.; Leutenegger, C.M. Granulomatous rhinitis due to Candida parapsilosis in a cat. J. Vet.-Diagn. Investig. 2013, 25, 596–598. [Google Scholar] [CrossRef]
- Tartor, Y.; Taha, M.; Mahboub, H.; El Ghamery, M. Yeast species associated with diseased fish: Occurrence, identification, experimental challenges and antifungal susceptibility testing. Aquaculture 2018, 488, 134–144. [Google Scholar] [CrossRef]
- Bogusławska-Wąs, E.; Dłubała, A.; Laskowska, M. The role of Rhodotorula mucilaginosa in selected biological process of wild fish. Fish Physiol. Biochem. 2019, 45, 511–521. [Google Scholar] [CrossRef]
- Santos, C.; Lima, N.; Sampaio, P.; Pais, C. Matrix-assisted laser desorption/ionization time-of-flight intact cell mass spectrometry (MALDI-TOF-ICMS) to detect emerging pathogenic Candida species. Diagn. Microbial. Infect. Dis. 2011, 71, 304–308. [Google Scholar] [CrossRef] [PubMed]
- Oliveira, M.M.E.; Santos, C.; Sampaio, P.; Romeo, O.; Almeida-Paes, R.; Pais, C.; Lima, N.; Zancopé-Oliveira, R.M. Development and optimization of a new MALDI-TOF protocol for identification of the Sporothrix species complex. Res. Microbiol. 2015, 166, 102–110. [Google Scholar] [CrossRef]
- Valero, C.; Buitrago, M.J.; Gago, S.; Quiles-Melero, I.; García-Rodríguez, J. A matrix-assisted laser desorption/ionization time of flight mass spectrometry reference database for the identification of Histoplasma capsulatum. Med. Mycol. 2017, 56, 307–314. [Google Scholar] [CrossRef] [PubMed]
- Jensen, R.H.; Arendrup, M.C. Candida palmioleophila: Characterization of a Previously Overlooked Pathogen and Its Unique Susceptibility Profile in Comparison with Five Related Species. J. Clin. Microbiol. 2011, 49, 549–556. [Google Scholar] [CrossRef]
- Flórez-Muñoz, S.V.; Gómez-Velásquez, J.C.; Loaiza-Díaz, N.; Soares, C.; Santos, C.; Lima, N.; Mesa-Arango, A.C. ITS rDNA Gene Analysis Versus MALDI-TOF MS For Identification of Neoscytalidium dimidiatum Isolated from Onychomycosis and Dermatomycosis Cases in Medellin (Colombia). Microorganisms 2019, 7, 306. [Google Scholar] [CrossRef]
- Matos, A.M.F.; Moreira, L.M.; Barczewski, B.F.; De Matos, L.X.; De Oliveira, J.B.V.; Pimentel, M.I.F.; Almeida-Paes, R.; Oliveira, M.G.; Pinto, T.C.A.; Lima, N.; et al. Identification by MALDI-TOF MS of Sporothrix brasiliensis Isolated from a Subconjunctival Infiltrative Lesion in an Immunocompetent Patient. Microorganisms 2019, 8, 22. [Google Scholar] [CrossRef] [PubMed]
- Chen, J.H.K.; Yam, W.-C.; Ngan, A.H.Y.; Fung, A.M.Y.; Woo, W.-L.; Yan, M.-K.; Choi, G.K.Y.; Ho, P.-L.; Cheng, V.C.C.; Yuen, K.-Y. Advantages of Using Matrix-Assisted Laser Desorption Ionization–Time of Flight Mass Spectrometry as a Rapid Diagnostic Tool for Identification of Yeasts and Mycobacteria in the Clinical Microbiological Laboratory. J. Clin. Microbiol. 2013, 51, 3981–3987. [Google Scholar] [CrossRef] [PubMed]
- Stavrou, A.A.; Lackner, M.; Lass-Flörl, C.; Boekhout, T. The changing spectrum of Saccharomycotina yeasts causing candidemia: Phylogeny mirrors antifungal susceptibility patterns for azole drugs and amphothericin B. FEMS Yeast. Res. 2019, 19, foz037. [Google Scholar] [CrossRef]

| Sample | Rioraja agassizii Individual | Methodologies | ||
|---|---|---|---|---|
| Chromoagar Candida | ITS Sequencing Partial | MALDI-TOF MS (Species/Score) | ||
| A84C1 | Male 1 | Candida parapsilosis | Candida parapsilosis | Candida parapsilosis—Score 1.77 |
| A84S1 | Male 1 | Candida parapsilosis | Candida parapsilosis | Candida parapsilosis—Score 1.78 |
| A84S2 | Male 1 | Candida tropicalis | Rhodotorula mucilaginosa | Rhodotorula mucilaginosa—Score 1.70 |
| A85C1 | Male 2 | Candida parapsilosis | Candida parapsilosis | Candida parapsilosis—Score 1.76 |
| A85C2 | Male 2 | Candida parapsilosis | Candida parapsilosis | Candida parapsilosis—Score 2.19 |
| A85S1 | Male 2 | Candida parapsilosis | Candida orthopsilosis | Candida orthopsilosis—Score 1.97 |
| A86S1 | Female 1 | Candida parapsilosis | Candida duobushaemulonis | Candida duobushaemulonis—Score 1.76 |
| A86S2 | Female 1 | Rhodotorula sp. | Rhodotorula mucilaginosa | Rhodotorula mucilaginosa—Score 1.73 |
| A87C1 | Female 2 | Candida krusei | Candida parapsilosis | Candida parapsilosis—Score 1.73 |
| A87S1 | Female 2 | Candida parapsilosis | Rhodotorula mucilaginosa | Rhodotorula mucilaginosa—Score 1.70 |
| A88S1 | Female 3 | Candida parapsilosis | Candida parapsilosis | Candida parapsilosis—Score 1.72 |
| A89S1 | Female 4 | Candida krusei | Candida parapsilosis | Candida parapsilosis—Score 2.19 |
Disclaimer/Publisher’s Note: The statements, opinions and data contained in all publications are solely those of the individual author(s) and contributor(s) and not of MDPI and/or the editor(s). MDPI and/or the editor(s) disclaim responsibility for any injury to people or property resulting from any ideas, methods, instructions or products referred to in the content. |
© 2023 by the authors. Licensee MDPI, Basel, Switzerland. This article is an open access article distributed under the terms and conditions of the Creative Commons Attribution (CC BY) license (https://creativecommons.org/licenses/by/4.0/).
Share and Cite
Oliveira, M.M.E.; Lopes, A.P.; Pinto, T.N.; da Costa, G.L.; Goes-Neto, A.; Hauser-Davis, R.A. A Novel One Health Approach concerning Yeast Present in the Oral Microbiome of the Endangered Rio Skate (Rioraja agassizii) from Southeastern Brazil. Microorganisms 2023, 11, 1969. https://doi.org/10.3390/microorganisms11081969
Oliveira MME, Lopes AP, Pinto TN, da Costa GL, Goes-Neto A, Hauser-Davis RA. A Novel One Health Approach concerning Yeast Present in the Oral Microbiome of the Endangered Rio Skate (Rioraja agassizii) from Southeastern Brazil. Microorganisms. 2023; 11(8):1969. https://doi.org/10.3390/microorganisms11081969
Chicago/Turabian StyleOliveira, Manoel Marques Evangelista, Amanda Pontes Lopes, Tatiane Nobre Pinto, Gisela Lara da Costa, Aristóteles Goes-Neto, and Rachel Ann Hauser-Davis. 2023. "A Novel One Health Approach concerning Yeast Present in the Oral Microbiome of the Endangered Rio Skate (Rioraja agassizii) from Southeastern Brazil" Microorganisms 11, no. 8: 1969. https://doi.org/10.3390/microorganisms11081969
APA StyleOliveira, M. M. E., Lopes, A. P., Pinto, T. N., da Costa, G. L., Goes-Neto, A., & Hauser-Davis, R. A. (2023). A Novel One Health Approach concerning Yeast Present in the Oral Microbiome of the Endangered Rio Skate (Rioraja agassizii) from Southeastern Brazil. Microorganisms, 11(8), 1969. https://doi.org/10.3390/microorganisms11081969

